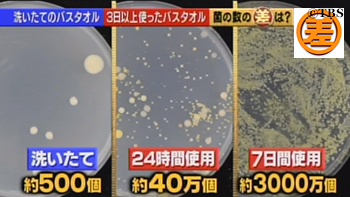

匿名さん

「バスタオル」何日使ったら洗う? 毎日、3日、2週間…みんなの意見は!?
>>43
汗を拭かなければならない程ならシャワーでもう一度流すだろ
匿名さん
>>50
何当たり前のこと言ってんの?
入浴前と後はシャワーで流すだろ
匿名さん
どっちが勝ちとか本人が良ければいい話
毎日洗いたい人、何日も使う人、好きにすりゃいい
匿名さん
>>6
毎日セックスするから 毎日洗う
匿名さん
洗濯したバスタオルは最初に枕カバーとして使う。そして朝まで枕カバーにしていたバスタオルで体を拭く。
以前は枕カバーもバスタオルも毎日とりかえていたけどコレで洗濯物が半分になった。
匿名さん
>>55
きたねえし負け惜しみ笑えるし
匿名さん
>>58
負け惜しみ?
でかいタオル使わないしな?
コレで勝ったとかつまらない生活してるんだね〜笑
匿名さん
>>58
スマホの方がもっと汚いってよ。
バスタオルで汚い汚い騒いでる奴は、普段どんな生活してるのかな?
匿名さん
ねぇ雑巾で体拭いて綺麗になったと思い込んでた人ってこのスレ見て今どんな気持ち?
ねぇどんな気持ち?
匿名さん
匿名さん
>>61
別に。
ふーんて感じ。
なんでそんなにはしゃいでるの?
匿名さん
>>63
大爆笑wwwwwwwwwwwwwww
腹いてぇwwwwwwwwwwwwwwww
匿名さん
>>64
なんで?
匿名さん
よく洗いきれていない汚い身体を拭くからバスタオルも汚くなるんだよ
匿名さん
使ったらそのつど洗う
ここ自分の不精を正当化しようと必死な人が多くてキモい
匿名さん
匿名さん
>>68
スマホとか毎日掃除してる?
匿名さん
布製品は水に濡れた途端に菌の繁殖が急激に始まります
匿名さん
雑巾さんフルボッコドンマイ
匿名さん
ここワキガのスレじゃないよ
バスタオルだよ
ワキガじゃなくてもバスタオル洗ってね